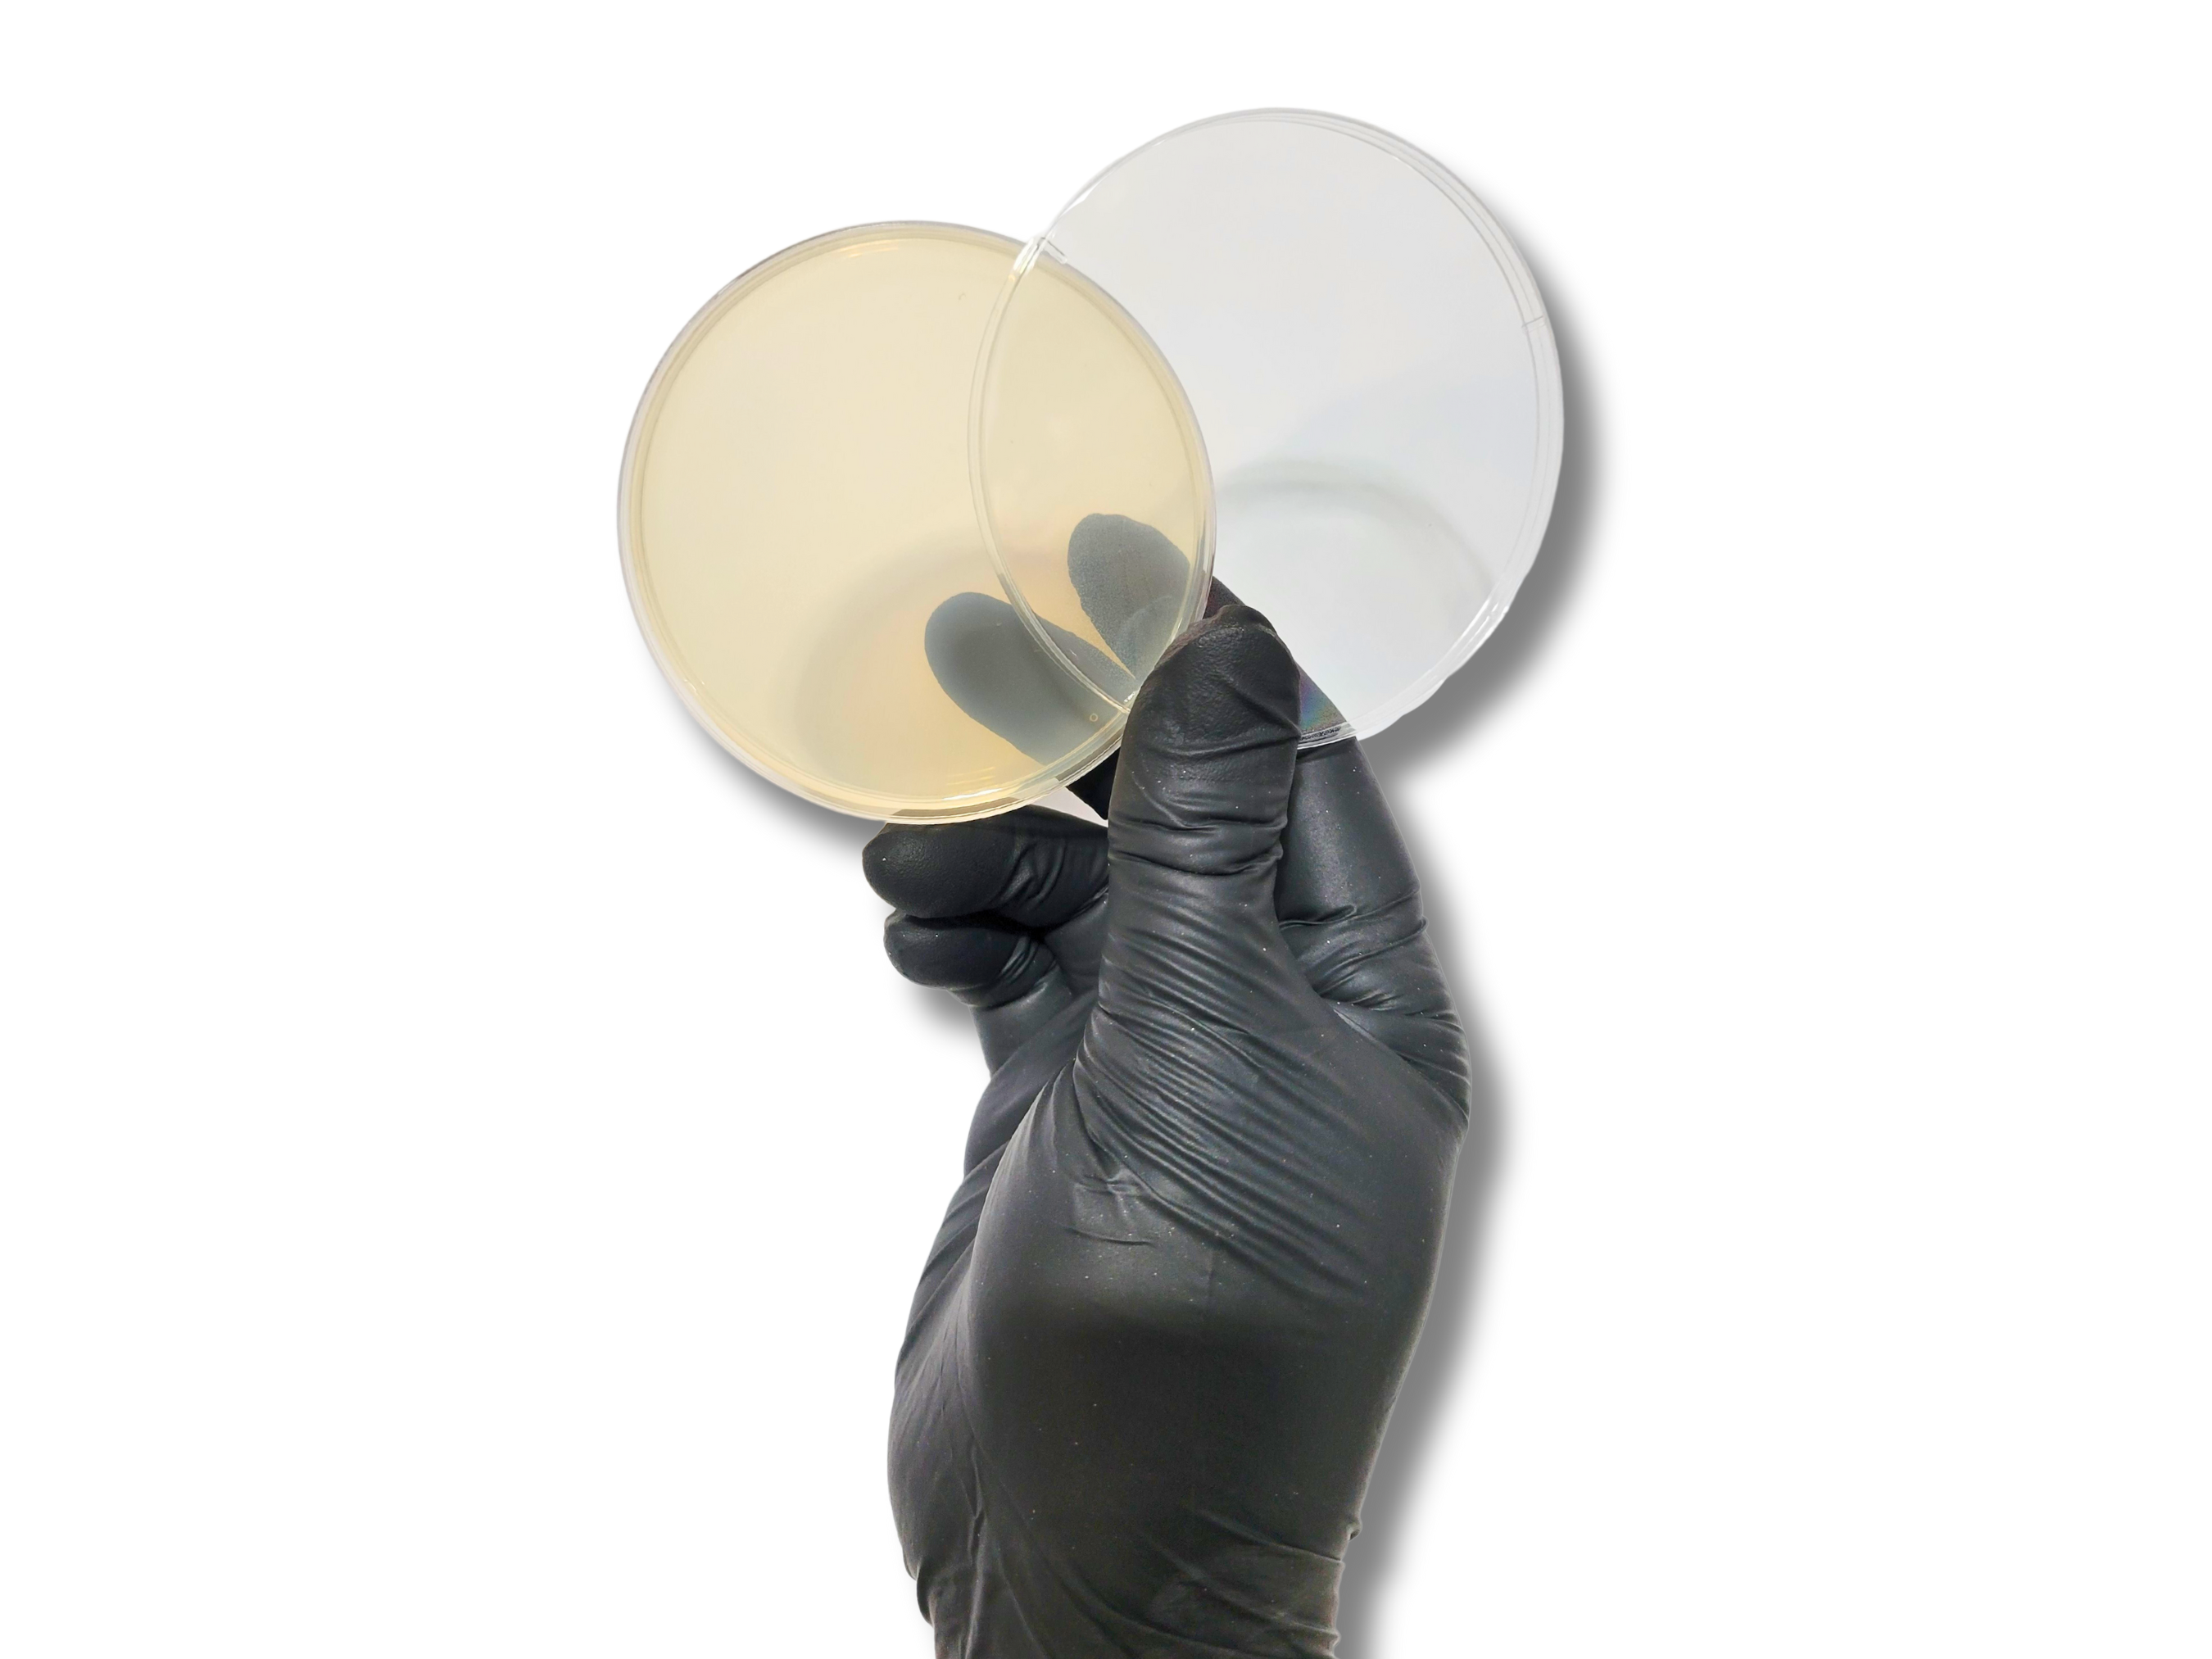

Pint LC + 4 MEA Plates
$22.00
| Quantity | Discount | Discounted price |
| 2 - 5 | 5% | $20.90 |
| 6 - 10 | 8% | $20.24 |
| 11 - 100 | 10% | $19.80 |
Allow 1-3 days for shipping. After product has shipped, we will email you with a tracking number.
This package includes a pint LC + 4 MEA plates, a superb choice for mushroom cultivation. It is ideal for both hobbyists and professionals in the field, offering a comprehensive solution for different stages of mushroom growth and development.
300 ML MALT MUSHROOM LIQUID CULTURE SOLUTION
Our high-quality 300 mL liquid culture solution is contained in a pint-sized jar, providing secure, leak-proof storage. The solution is fortified with malt nutrients, which significantly enhance mycelium growth. Its key features include:
- Nutrient-Rich Solution: 300ml per jar, designed to encourage swift mycelium development.
- Effective Mixing: Includes a magnetic stir bar for consistent nutrient and mycelium distribution.
- Guaranteed Sterility Upon Delivery: Features a self-healing injection port and a 0.22 μm syringe filter for maintaining a sterile environment.
VENDOR’S CHOICE MEA PLATES
These MEA plates are carefully poured, pressure sterilized, then sealed in front of a laminar flowhood, ensuring their sterility. Their features are:
- Color Possibilities: Various colors may include red, turquoise, peach, blue, green, orange, pink, purple, clear, and/or activated charcoal (black).
- Plate Specifications: Dimensions of 90/100mm x 15mm.
- Nutrient-Enriched: Contains malt extract agar, optimal for mycelium growth and pure culture isolation.
WHY THIS COMBINATION IS OPTIMAL FOR MUSHROOM CULTIVATION
The combination of the 300 mL liquid culture solution with the Vendor’s Choice MEA Plates, in conjunction with a spore syringe, constitutes a comprehensive approach to mushroom cultivation. This setup covers different phases of the process, from spore inoculation to mycelium expansion.
Initially, the spore syringe is utilized for inoculating the MEA plates, a critical step for the ‘clean-up’ phase aimed at removing contaminants from the spores. The process includes:
- Inoculation: Introducing a small quantity of the spore solution onto the agar surface of the MEA plates.
- Incubation and Monitoring: The plates are incubated at a suitable temperature, with the grower observing for mycelium growth and potential contaminants.
- Selection of Healthy Mycelium: Identifying and selecting uncontaminated mycelium as it grows.
- Transfer to Liquid Culture: Sterile transfer of a healthy mycelium section from the agar to the liquid culture jar.
In the liquid culture jar, the mycelium fragment thrives in a nutrient-dense liquid, enabling rapid and vigorous growth. The transparent jar facilitates easy monitoring of this growth, while the magnetic stir bar ensures even distribution of nutrients and mycelium, promoting uniform development.
This combined approach with our Pint LC + 4 MEA Plates — starting from spore syringes, progressing to MEA plates for initial growth and cleaning, and finally transferring to a liquid culture jar — offers a controlled and effective way to cultivate mushrooms. It is especially advantageous for preserving the purity of the mushroom strain and ensuring robust mycelium development, critical for successful mushroom cultivation.